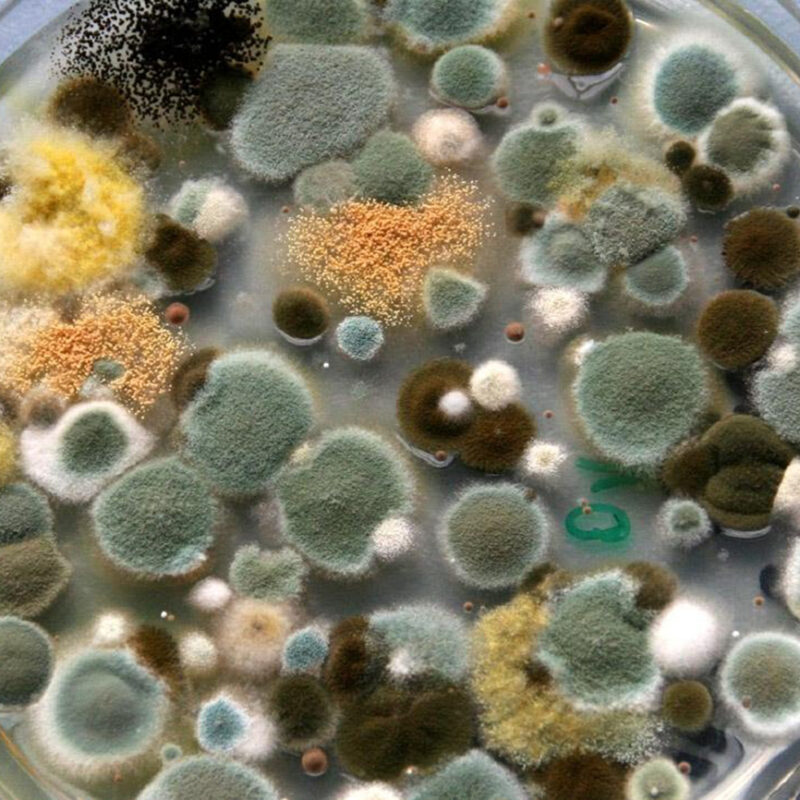

Neueste Beiträge
- Quecksilber: Der stille Zellzerstörer: Wie Quecksilber aus Umwelt und Amalgam unsere Mitochondrien, Gene und Gehirne schädigen können
- Ketamin-assistierte Therapie: Hoffnung für Therapie-resistenten Psychischen Erkrankungen?
- Schimmel: Das Black Hole der Schulmedizin?
- Rückenschmerzen: Warum „Bandscheibenvorfall“ nicht die ganze Wahrheit ist
- Beim Hausarzt „Alles in Ordnung“ – und trotzdem erschöpft?
Neueste Kommentare
Es sind keine Kommentare vorhanden.